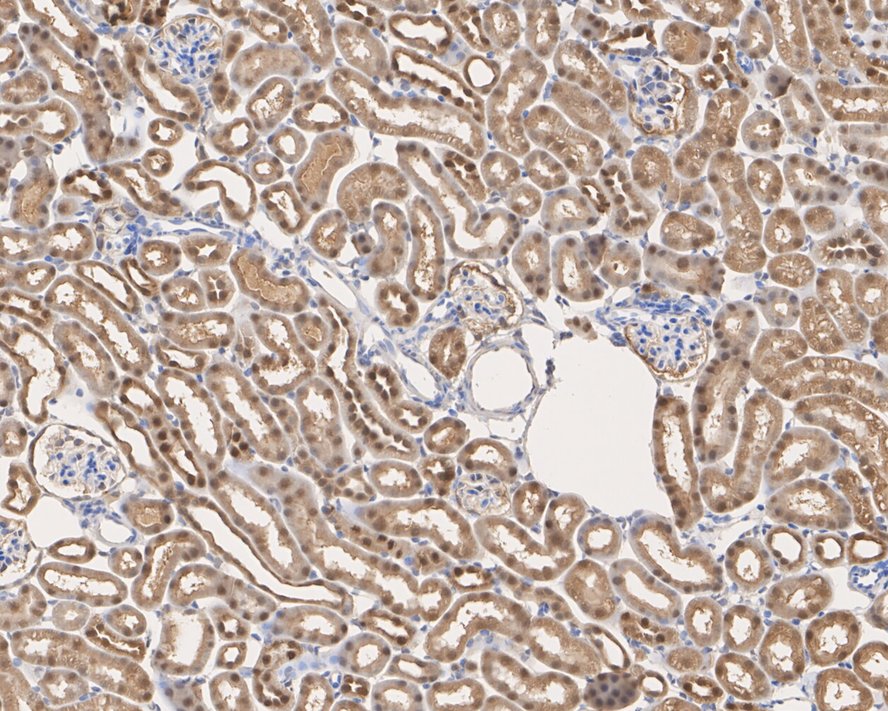

Peroxiredoxin 5 Recombinant Rabbit Monoclonal Antibody [PSH03-90] - BSA and Azide free
Rmb: 5600 特惠
产品规格
Catalog# HA750915
Peroxiredoxin 5 Recombinant Rabbit Monoclonal Antibody [PSH03-90] - BSA and Azide free
-
WB
-
IHC-P
-
IF-Cell
-
FC
-
IP
-
Human
-
Mouse
-
Rat
-
HA722061
含抗保成分
-
unconjugated
Safety datasheet
概述
产品名称
Peroxiredoxin 5 Recombinant Rabbit Monoclonal Antibody [PSH03-90] - BSA and Azide free
抗体类型
Recombinant Rabbit monoclonal Antibody
免疫原
Recombinant protein within human Peroxiredoxin 5 aa 31-214 / 214.
种属反应性
Human, Mouse, Rat
验证应用
WB, IHC-P, IF-Cell, FC, IP
分子量
Predicted band size: 22 kDa
阳性对照
HeLa cell lysate, A549 cell lysate, MCF7 cell lysate, mouse liver tissue lysate, mouse kidney tissue lysate, rat liver tissue lysate, rat kidney tissue lysate, HepG2 cell lysate, Neuro-2a cell lysate, NIH/3T3 cell lysate, PC-12 cell lysate, C6 cell lysate, human kidney tissue, human liver tissue, mouse kidney tissue, mouse liver tissue, rat kidney tissue, rat liver tissue, HeLa, F9, PC-12, C6.
偶联
unconjugated
克隆号
PSH03-90
产品特性
形态
Liquid
浓度
存放说明
Store at +4℃ after thawing. Aliquot store at -20℃. Avoid repeated freeze / thaw cycles.
存储缓冲液
1*PBS (pH7.4).
亚型
IgG
纯化方式
Protein A affinity purified.
应用稀释度
-
WB
-
1:20,000-1:50,000
-
IHC-P
-
1:10,000
-
IF-Cell
-
1:100
-
FC
-
1:1,000
-
IP
-
1-2μg/sample
靶点
功能
Peroxiredoxin-5 (PRDX5), mitochondrial is a protein that in humans is encoded by the PRDX5 gene, located on chromosome 11. This gene encodes a member of the six-member peroxiredoxin family of antioxidant enzymes. Like the other five members, PRDX5 is widely expressed in tissues but differs by its large subcellular distribution. In human cells, it has been shown that PRDX5 can be localized to mitochondria, peroxisomes, the cytosol, and the nucleus. Human PRDX5 is identified by virtue of the sequence homologies to yeast peroxisomal antioxidant enzyme PMP20. Biochemically, PRDX5 is a peroxidase that can use cytosolic or mitochondrial thioredoxins to reduce alkyl hydroperoxides or peroxynitrite with high rate constants in the 106 to 107 M−1s−1 range, whereas its reaction with hydrogen peroxide is more modest, in the 105 M−1s−1 range. So far, PRDX5 has been shown to be a cytoprotective antioxidant enzyme that inhibits endogenous or exogenous peroxide accumulation.
背景文献
1. Agborbesong E et al. Prdx5 regulates DNA damage response through autophagy-dependent Sirt2-p53 axis. Hum Mol Genet. 2023 Jan
2. Chen X et al. PRDX5 as a novel binding partner in Nrf2-mediated NSCLC progression under oxidative stress. Aging (Albany NY). 2020 Jan
亚细胞定位
Mitochondrion; Cytoplasm, Peroxisome matrix.
别名
ACR1 antibody
Alu co repressor 1 antibody
Alu corepressor 1 antibody
Antioxidant enzyme B166 antibody
AOEB166 antibody
B166 antibody
epididymis secretory protein Li 55 antibody
HEL-S-55 antibody
Liver tissue 2D-page spot 71B antibody
mitochondrial antibody
展开ACR1 antibody
Alu co repressor 1 antibody
Alu corepressor 1 antibody
Antioxidant enzyme B166 antibody
AOEB166 antibody
B166 antibody
epididymis secretory protein Li 55 antibody
HEL-S-55 antibody
Liver tissue 2D-page spot 71B antibody
mitochondrial antibody
Peroxiredoxin 5, mitochondrial antibody
Peroxiredoxin V antibody
Peroxiredoxin-5 antibody
Peroxisomal antioxidant enzyme antibody
PLP antibody
PMP20 antibody
PRDX 5 antibody
PRDX5 antibody
PRDX5_HUMAN antibody
PRDX6 antibody
Prx-V antibody
PRXV antibody
SBBI10 antibody
Thioredoxin peroxidase PMP20 antibody
Thioredoxin reductase antibody
TPx type VI antibody
折叠图片
-

Western blot analysis of Peroxiredoxin 5 on different lysates with Rabbit anti-Peroxiredoxin 5 antibody (HA750915) at 1/50,000 dilution and competitor's antibody at 1/10,000 dilution.
Lane 1: HeLa cell lysate (10 µg/Lane)
Lane 2: A549 cell lysate (10 µg/Lane)
Lane 3: MCF7 cell lysate (10 µg/Lane)
Lane 4: Mouse liver tissue lysate (15 µg/Lane)
Lane 5: Mouse kidney tissue lysate (15 µg/Lane)
Lane 6: Rat liver tissue lysate (15 µg/Lane)
Lane 7: Rat kidney tissue lysate (15 µg/Lane)
Predicted band size: 22 kDa
Observed band size: 17 kDa
Exposure time: 10 seconds; ECL: K1801;
4-20% SDS-PAGE gel.
Proteins were transferred to a PVDF membrane and blocked with 5% NFDM/TBST for 1 hour at room temperature. The primary antibody (HA750915) at 1/50,000 dilution and competitor's antibody at 1/10,000 dilution were used in 5% NFDM/TBST at 4℃ overnight. Goat Anti-Rabbit IgG - HRP Secondary Antibody (HA1001) at 1/200,000 dilution was used for 1 hour at room temperature. -

Western blot analysis of Peroxiredoxin 5 on different lysates with Rabbit anti-Peroxiredoxin 5 antibody (HA750915) at 1/20,000 dilution.
Lane 1: HeLa cell lysate (10 µg/Lane)
Lane 2: HepG2 cell lysate (10 µg/Lane)
Lane 3: A549 cell lysate (10 µg/Lane)
Lane 4: MCF7 cell lysate (10 µg/Lane)
Predicted band size: 22 kDa
Observed band size: 17 kDa
Exposure time: 6 seconds; ECL: K1801;
4-20% SDS-PAGE gel.
Proteins were transferred to a PVDF membrane and blocked with 5% NFDM/TBST for 1 hour at room temperature. The primary antibody (HA750915) at 1/20,000 dilution was used in 5% NFDM/TBST at 4℃ overnight. Goat Anti-Rabbit IgG - HRP Secondary Antibody (HA1001) at 1/50,000 dilution was used for 1 hour at room temperature. -

Western blot analysis of Peroxiredoxin 5 on different lysates with Rabbit anti-Peroxiredoxin 5 antibody (HA750915) at 1/20,000 dilution.
Lane 1: Neuro-2a cell lysate
Lane 2: NIH/3T3 cell lysate
Lane 3: PC-12 cell lysate
Lane 4: C6 cell lysate
Lysates/proteins at 20 µg/Lane.
Predicted band size: 22 kDa
Observed band size: 17 kDa
Exposure time: 1 minute 40 seconds; ECL: K1801;
4-20% SDS-PAGE gel.
Proteins were transferred to a PVDF membrane and blocked with 5% NFDM/TBST for 1 hour at room temperature. The primary antibody (HA750915) at 1/20,000 dilution was used in 5% NFDM/TBST at 4℃ overnight. Goat Anti-Rabbit IgG - HRP Secondary Antibody (HA1001) at 1/50,000 dilution was used for 1 hour at room temperature. -

Immunocytochemistry analysis of HeLa cells labeling Peroxiredoxin 5 with Rabbit anti-Peroxiredoxin 5 antibody (HA750915) at 1/100 dilution.
Cells were fixed in 4% paraformaldehyde for 20 minutes at room temperature, permeabilized with 0.1% Triton X-100 in PBS for 5 minutes at room temperature, then blocked with 1% BSA in 10% negative goat serum for 1 hour at room temperature. Cells were then incubated with Rabbit anti-Peroxiredoxin 5 antibody (HA750915) at 1/100 dilution in 1% BSA in PBST overnight at 4 ℃. Goat Anti-Rabbit IgG H&L (iFluor™ 488, HA1121) was used as the secondary antibody at 1/1,000 dilution. PBS instead of the primary antibody was used as the secondary antibody only control. Nuclear DNA was labelled in blue with DAPI.
Beta tubulin (M1305-2, red) was stained at 1/100 dilution overnight at +4℃. Goat Anti-Mouse IgG H&L (iFluor™ 594, HA1126) was used as the secondary antibody at 1/1,000 dilution. -

Immunocytochemistry analysis of F9 cells labeling Peroxiredoxin 5 with Rabbit anti-Peroxiredoxin 5 antibody (HA750915) at 1/100 dilution.
Cells were fixed in 4% paraformaldehyde for 20 minutes at room temperature, permeabilized with 0.1% Triton X-100 in PBS for 5 minutes at room temperature, then blocked with 1% BSA in 10% negative goat serum for 1 hour at room temperature. Cells were then incubated with Rabbit anti-Peroxiredoxin 5 antibody (HA750915) at 1/100 dilution in 1% BSA in PBST overnight at 4 ℃. Goat Anti-Rabbit IgG H&L (iFluor™ 488, HA1121) was used as the secondary antibody at 1/1,000 dilution. PBS instead of the primary antibody was used as the secondary antibody only control. Nuclear DNA was labelled in blue with DAPI.
Beta tubulin (M1305-2, red) was stained at 1/100 dilution overnight at +4℃. Goat Anti-Mouse IgG H&L (iFluor™ 594, HA1126) was used as the secondary antibody at 1/1,000 dilution. -

Immunocytochemistry analysis of PC-12 cells labeling Peroxiredoxin 5 with Rabbit anti-Peroxiredoxin 5 antibody (HA750915) at 1/100 dilution.
Cells were fixed in 4% paraformaldehyde for 20 minutes at room temperature, permeabilized with 0.1% Triton X-100 in PBS for 5 minutes at room temperature, then blocked with 1% BSA in 10% negative goat serum for 1 hour at room temperature. Cells were then incubated with Rabbit anti-Peroxiredoxin 5 antibody (HA750915) at 1/100 dilution in 1% BSA in PBST overnight at 4 ℃. Goat Anti-Rabbit IgG H&L (iFluor™ 488, HA1121) was used as the secondary antibody at 1/1,000 dilution. PBS instead of the primary antibody was used as the secondary antibody only control. Nuclear DNA was labelled in blue with DAPI.
Beta tubulin (M1305-2, red) was stained at 1/100 dilution overnight at +4℃. Goat Anti-Mouse IgG H&L (iFluor™ 594, HA1126) was used as the secondary antibody at 1/1,000 dilution. -

Immunohistochemical analysis of paraffin-embedded human kidney tissue with Rabbit anti-Peroxiredoxin 5 antibody (HA750915) at 1/10,000 dilution.
The section was pre-treated using heat mediated antigen retrieval with sodium citrate buffer (pH 6.0) (high pressure) for 2 minutes. The tissues were blocked in 1% BSA for 20 minutes at room temperature, washed with ddH2O and PBS, and then probed with the primary antibody (HA750915) at 1/10,000 dilution for 1 hour at room temperature. The detection was performed using an HRP conjugated compact polymer system. DAB was used as the chromogen. Tissues were counterstained with hematoxylin and mounted with DPX. -

Immunohistochemical analysis of paraffin-embedded human liver tissue with Rabbit anti-Peroxiredoxin 5 antibody (HA750915) at 1/10,000 dilution.
The section was pre-treated using heat mediated antigen retrieval with sodium citrate buffer (pH 6.0) (high pressure) for 2 minutes. The tissues were blocked in 1% BSA for 20 minutes at room temperature, washed with ddH2O and PBS, and then probed with the primary antibody (HA750915) at 1/10,000 dilution for 1 hour at room temperature. The detection was performed using an HRP conjugated compact polymer system. DAB was used as the chromogen. Tissues were counterstained with hematoxylin and mounted with DPX. -
Immunohistochemical analysis of paraffin-embedded mouse kidney tissue with Rabbit anti-Peroxiredoxin 5 antibody (HA750915) at 1/10,000 dilution.
The section was pre-treated using heat mediated antigen retrieval with sodium citrate buffer (pH 6.0) (high pressure) for 2 minutes. The tissues were blocked in 1% BSA for 20 minutes at room temperature, washed with ddH2O and PBS, and then probed with the primary antibody (HA750915) at 1/10,000 dilution for 1 hour at room temperature. The detection was performed using an HRP conjugated compact polymer system. DAB was used as the chromogen. Tissues were counterstained with hematoxylin and mounted with DPX. -

Immunohistochemical analysis of paraffin-embedded mouse liver tissue with Rabbit anti-Peroxiredoxin 5 antibody (HA750915) at 1/10,000 dilution.
The section was pre-treated using heat mediated antigen retrieval with sodium citrate buffer (pH 6.0) (high pressure) for 2 minutes. The tissues were blocked in 1% BSA for 20 minutes at room temperature, washed with ddH2O and PBS, and then probed with the primary antibody (HA750915) at 1/10,000 dilution for 1 hour at room temperature. The detection was performed using an HRP conjugated compact polymer system. DAB was used as the chromogen. Tissues were counterstained with hematoxylin and mounted with DPX. -

Immunohistochemical analysis of paraffin-embedded rat kidney tissue with Rabbit anti-Peroxiredoxin 5 antibody (HA750915) at 1/10,000 dilution.
The section was pre-treated using heat mediated antigen retrieval with sodium citrate buffer (pH 6.0) (high pressure) for 2 minutes. The tissues were blocked in 1% BSA for 20 minutes at room temperature, washed with ddH2O and PBS, and then probed with the primary antibody (HA750915) at 1/10,000 dilution for 1 hour at room temperature. The detection was performed using an HRP conjugated compact polymer system. DAB was used as the chromogen. Tissues were counterstained with hematoxylin and mounted with DPX. -

Immunohistochemical analysis of paraffin-embedded rat liver tissue with Rabbit anti-Peroxiredoxin 5 antibody (HA750915) at 1/10,000 dilution.
The section was pre-treated using heat mediated antigen retrieval with sodium citrate buffer (pH 6.0) (high pressure) for 2 minutes. The tissues were blocked in 1% BSA for 20 minutes at room temperature, washed with ddH2O and PBS, and then probed with the primary antibody (HA750915) at 1/10,000 dilution for 1 hour at room temperature. The detection was performed using an HRP conjugated compact polymer system. DAB was used as the chromogen. Tissues were counterstained with hematoxylin and mounted with DPX. -

Flow cytometric analysis of HeLa cells labeling Peroxiredoxin 5.
Cells were fixed and permeabilized. Then stained with the primary antibody (HA750915, 1μg/mL) (red) compared with Rabbit IgG Isotype Control (green). After incubation of the primary antibody at +4℃ for an hour, the cells were stained with a iFluor™ 488 conjugate-Goat anti-Rabbit IgG Secondary antibody (HA1121) at 1/1,000 dilution for 30 minutes at +4℃. Unlabelled sample was used as a control (cells without incubation with primary antibody; black). -

Flow cytometric analysis of F9 cells labeling Peroxiredoxin 5.
Cells were fixed and permeabilized. Then stained with the primary antibody (HA750915, 1μg/mL) (red) compared with Rabbit IgG Isotype Control (green). After incubation of the primary antibody at +4℃ for an hour, the cells were stained with a iFluor™ 488 conjugate-Goat anti-Rabbit IgG Secondary antibody (HA1121) at 1/1,000 dilution for 30 minutes at +4℃. Unlabelled sample was used as a control (cells without incubation with primary antibody; black). -

Flow cytometric analysis of C6 cells labeling Peroxiredoxin 5.
Cells were fixed and permeabilized. Then stained with the primary antibody (HA750915, 1μg/mL) (green) compared with Rabbit IgG Isotype Control (red). After incubation of the primary antibody at +4℃ for an hour, the cells were stained with a iFluor™ 488 conjugate-Goat anti-Rabbit IgG Secondary antibody (HA1121) at 1/1,000 dilution for 30 minutes at +4℃. Unlabelled sample was used as a control (cells without incubation with primary antibody; black). -

Peroxiredoxin 5 was immunoprecipitated in 0.2mg HeLa cell lysate with HA750915 at 2 µg/10 µl beads. Western blot was performed from the immunoprecipitate using HA750915 at 1/5,000 dilution. Anti-Rabbit IgG for IP Nano-secondary antibody (NBI01H) at 1/5,000 dilution was used for 1 hour at room temperature.
Lane 1: HeLa cell lysate (input)
Lane 2: HA750915 IP in HeLa cell lysate
Lane 3: Rabbit IgG instead of HA750915 in HeLa cell lysate
Blocking/Dilution buffer: 5% NFDM/TBST
Exposure time: 43 seconds; ECL: K1801 -

Peroxiredoxin 5 was immunoprecipitated in 0.2mg PC-12 cell lysate with HA750915 at 2 µg/10 µl beads. Western blot was performed from the immunoprecipitate using HA750915 at 1/5,000 dilution. Anti-Rabbit IgG for IP Nano-secondary antibody (NBI01H) at 1/5,000 dilution was used for 1 hour at room temperature.
Lane 1: PC-12 cell lysate (input)
Lane 2: HA750915 IP in PC-12 cell lysate
Lane 3: Rabbit IgG instead of HA750915 in PC-12 cell lysate
Blocking/Dilution buffer: 5% NFDM/TBST
Exposure time: 43 seconds; ECL: K1801
请注意: All products are "FOR RESEARCH USE ONLY AND ARE NOT INTENDED FOR DIAGNOSTIC OR THERAPEUTIC USE"


 浙公网安备 33019202000643号
浙公网安备 33019202000643号